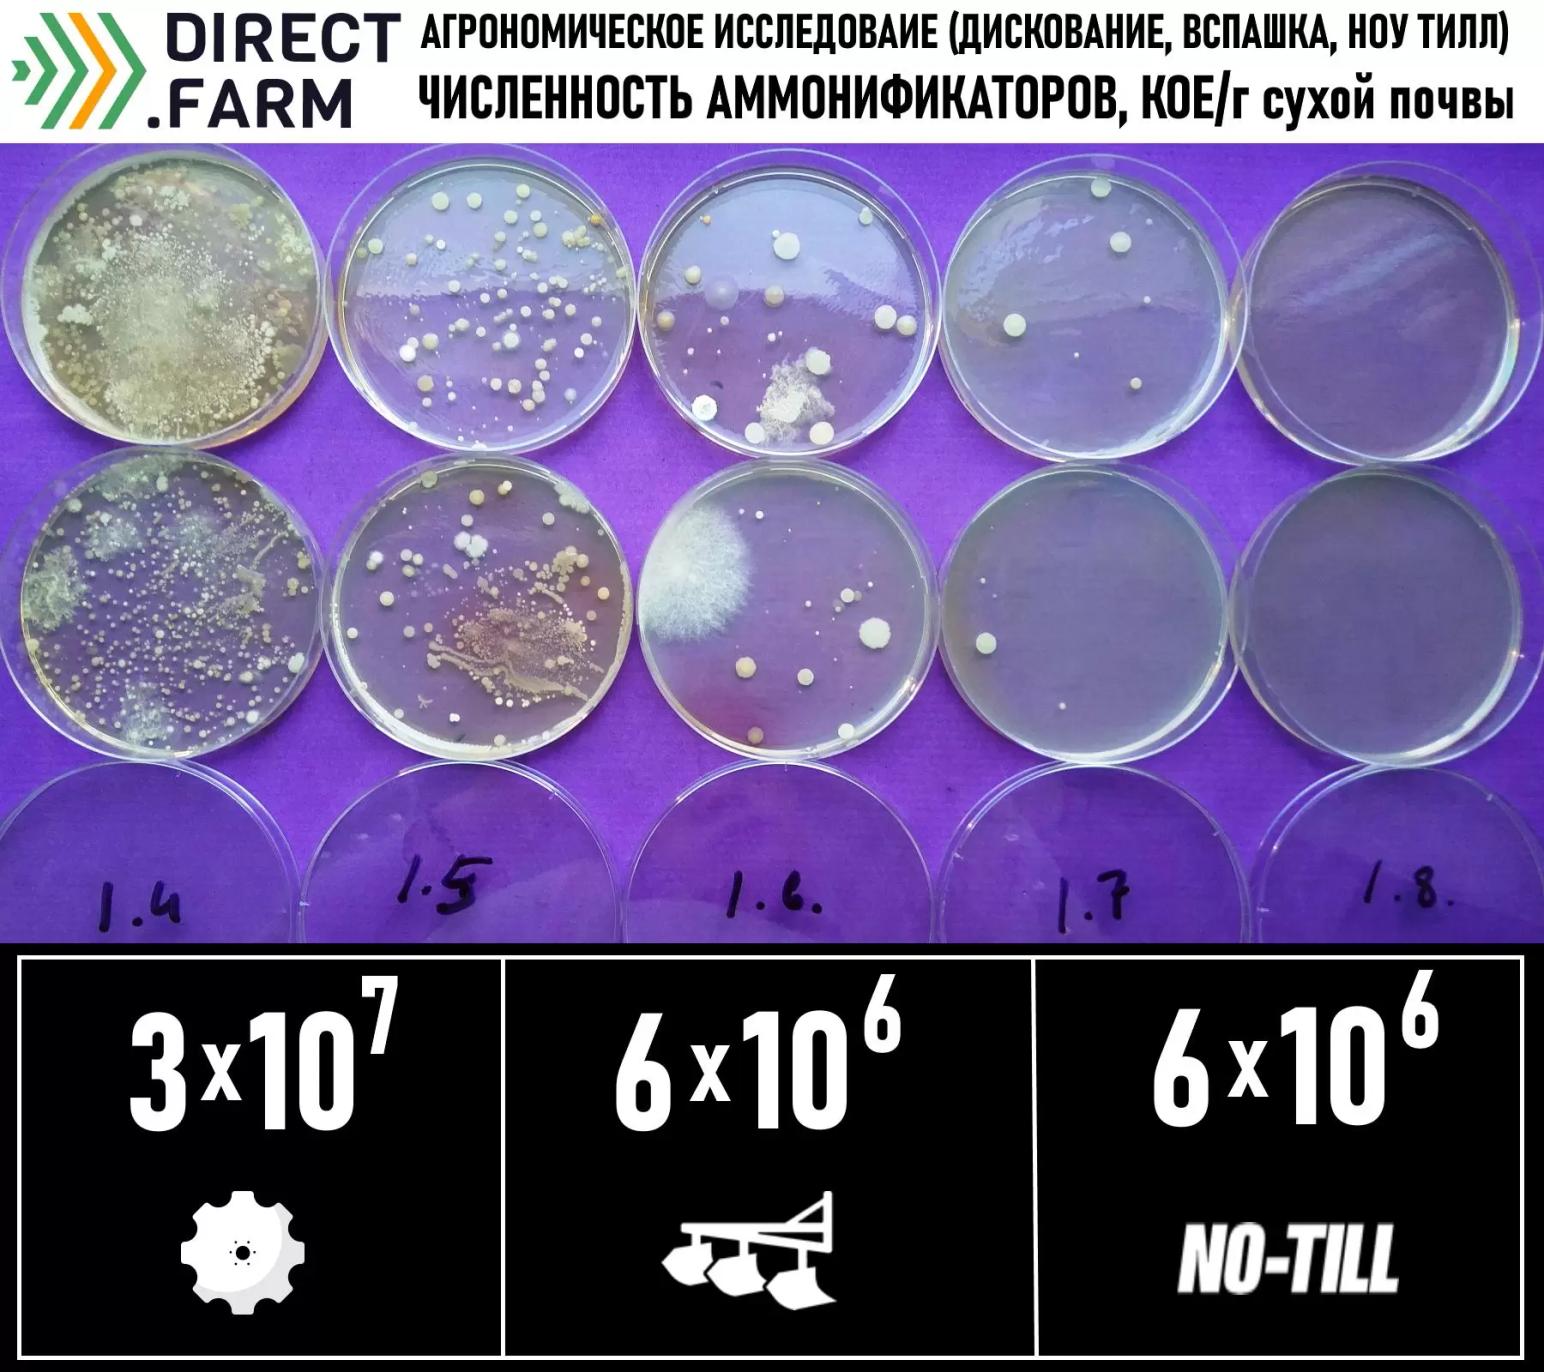

Аммонификация (результаты агрономического исследования)
Аммонификация – микробиологический процесс разложения азотсодержащих органических соединений с образованием свободного аммиака.
Аммонификаторы (результаты анализа на вариантах с различными технологиями обработки почвы):
Концентрация аммонификаторов в почвенных образцах составила (КОЕ/г сухой почвы):
· «Дискование» – 3*10 в седьмой степени;
· «Вспашка» – 6*10 в шестой степени;
· «Ноу Тилл» – 6*10 в шестой степени.
Мы не получили дополнительных комментариев от лаборатории, но вывод очевиден и количество аммонификатов максимально на варианте с дискованием и меньше, но одинаково на вариантах со вспашкой и без обработок почвы.
Наиболее активно в процессах аммонификации участвуют представители бактерий родов Pseudomonas, Bacillus, Clostridium и Proteus, представители грибов порядка Mucorales, родов Aspergillus, Trichoderma и др.
Скорее всего ранее опубликованные результаты по микологическому анализу объяснят данную закономерность (картинка прикреплена к посту)
А как вы думаете с чем связана данная закономерность? (пишите свои мнения в комментариях)
Другие результаты исследования:
Твердость сложения почвы пахотного слоя
Содержание гумуса в почве
Нитрификационная способность почвы

1 комментарий